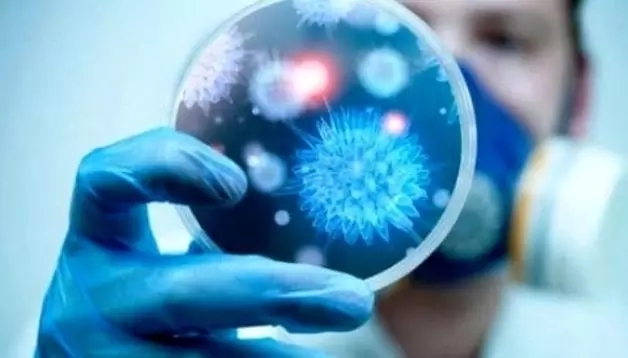

新欧洲侨报编译消息:为什么水塔里的军团菌竟让意大利连死数人?为什么小小的感冒也能“牺牲”数人?一种超级细菌正象幽灵一样在意大利悄然蔓延。一旦感染这种病菌,常常会引起败血症或肺炎等并发症,从而危及性命。数据显示,欧洲每年约33000人死于超级细菌,其中意大利和希腊是重灾区,意大利感染致死者占到全欧洲的三分之一。


日前意大利疾病预防控制中心发出警告,提醒人们重视超级细菌带来的可怕后果。2017年意大利死于超级细菌的有10762人,其中以1岁以下的幼儿和65岁以上的银发族居多。千百年来,细菌感染曾是无药可治的绝症,造成了难以计数的人类死亡。自从1928弗莱明发明青霉素对抗细菌感染以来,人类的平均寿命明显增加。人们乐观地以为,抗菌素已经彻底解决了细菌感染的问题。但事实清楚地告诉我们,抗菌药物是一把双刃剑。一方面它能杀死细菌,另一方面总有一些狡猾的细菌没有被杀死,而是产生耐药基因,于是出现了耐药性越来越强的超级耐药菌。人体一旦感染了这样的超级细菌,就会出现无药可医的境地。目前超级细菌主要有:耐甲氧西林金黄色葡萄球菌、耐多药肺炎链球菌、万古霉素肠球菌、多重耐药性结核杆菌、多重耐药鲍曼不动杆菌以及最新发现的携带NDM-1基因的大肠杆菌和肺炎克雷伯菌等。由于大部分抗生素对其不起作用,它们对人类健康已造成极大的危害。如耐青霉素的肺炎链球菌,过去对青霉素、红霉素、磺胺等药品都很敏感,现在几乎刀枪不入。世界卫生组织预测,到2050年超级细菌将成为全球的头号杀手。意大利疾病预防控制中心为此呼吁,必须通过免疫接种、供水改善、环境卫生和良好的畜牧业来减少对抗微生物药物的需求,同时要加强药物供应的监控,并在合理规范内使用抗菌药物,尤其要限制万古霉素的滥用。日常生活中,洗手是预防病原菌蔓延的最重要的措施,因此必须加强洗手重要性的宣传和教育。
日前意大利疾病预防控制中心发出警告,提醒人们重视超级细菌带来的可怕后果。2017年意大利死于超级细菌的有10762人,其中以1岁以下的幼儿和65岁以上的银发族居多。千百年来,细菌感染曾是无药可治的绝症,造成了难以计数的人类死亡。自从1928弗莱明发明青霉素对抗细菌感染以来,人类的平均寿命明显增加。人们乐观地以为,抗菌素已经彻底解决了细菌感染的问题。但事实清楚地告诉我们,抗菌药物是一把双刃剑。一方面它能杀死细菌,另一方面总有一些狡猾的细菌没有被杀死,而是产生耐药基因,于是出现了耐药性越来越强的超级耐药菌。人体一旦感染了这样的超级细菌,就会出现无药可医的境地。目前超级细菌主要有:耐甲氧西林金黄色葡萄球菌、耐多药肺炎链球菌、万古霉素肠球菌、多重耐药性结核杆菌、多重耐药鲍曼不动杆菌以及最新发现的携带NDM-1基因的大肠杆菌和肺炎克雷伯菌等。由于大部分抗生素对其不起作用,它们对人类健康已造成极大的危害。如耐青霉素的肺炎链球菌,过去对青霉素、红霉素、磺胺等药品都很敏感,现在几乎刀枪不入。世界卫生组织预测,到2050年超级细菌将成为全球的头号杀手。意大利疾病预防控制中心为此呼吁,必须通过免疫接种、供水改善、环境卫生和良好的畜牧业来减少对抗微生物药物的需求,同时要加强药物供应的监控,并在合理规范内使用抗菌药物,尤其要限制万古霉素的滥用。日常生活中,洗手是预防病原菌蔓延的最重要的措施,因此必须加强洗手重要性的宣传和教育。
日前意大利疾病预防控制中心发出警告,提醒人们重视超级细菌带来的可怕后果。2017年意大利死于超级细菌的有10762人,其中以1岁以下的幼儿和65岁以上的银发族居多。千百年来,细菌感染曾是无药可治的绝症,造成了难以计数的人类死亡。自从1928弗莱明发明青霉素对抗细菌感染以来,人类的平均寿命明显增加。人们乐观地以为,抗菌素已经彻底解决了细菌感染的问题。但事实清楚地告诉我们,抗菌药物是一把双刃剑。一方面它能杀死细菌,另一方面总有一些狡猾的细菌没有被杀死,而是产生耐药基因,于是出现了耐药性越来越强的超级耐药菌。人体一旦感染了这样的超级细菌,就会出现无药可医的境地。目前超级细菌主要有:耐甲氧西林金黄色葡萄球菌、耐多药肺炎链球菌、万古霉素肠球菌、多重耐药性结核杆菌、多重耐药鲍曼不动杆菌以及最新发现的携带NDM-1基因的大肠杆菌和肺炎克雷伯菌等。由于大部分抗生素对其不起作用,它们对人类健康已造成极大的危害。如耐青霉素的肺炎链球菌,过去对青霉素、红霉素、磺胺等药品都很敏感,现在几乎刀枪不入。世界卫生组织预测,到2050年超级细菌将成为全球的头号杀手。意大利疾病预防控制中心为此呼吁,必须通过免疫接种、供水改善、环境卫生和良好的畜牧业来减少对抗微生物药物的需求,同时要加强药物供应的监控,并在合理规范内使用抗菌药物,尤其要限制万古霉素的滥用。日常生活中,洗手是预防病原菌蔓延的最重要的措施,因此必须加强洗手重要性的宣传和教育。
暂无评论,快来抢沙发吧!首评可提升互动曝光。